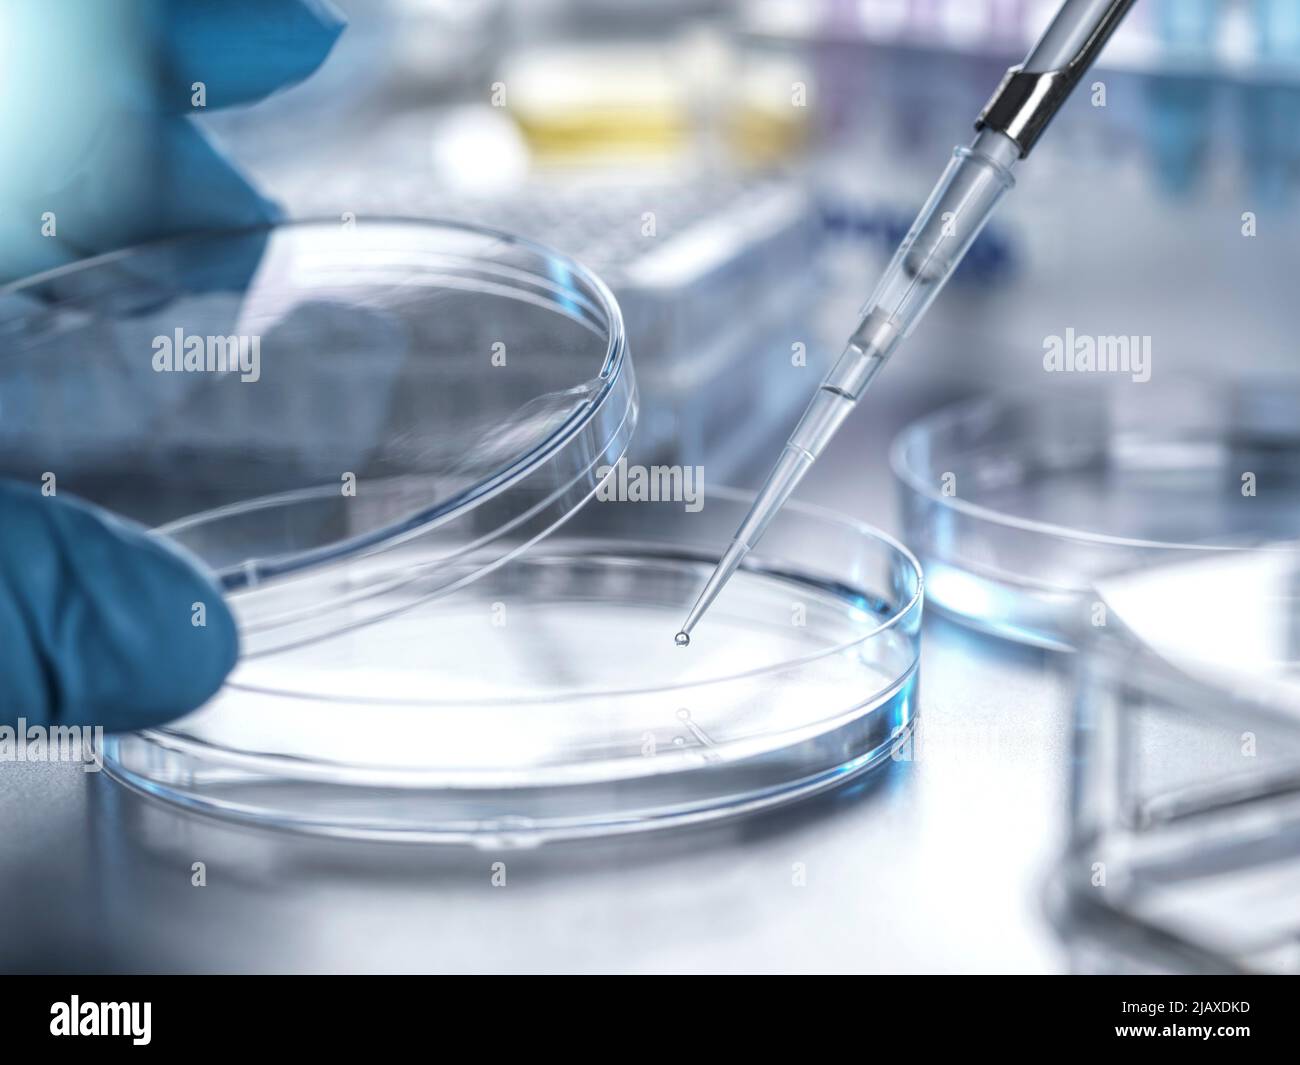
Recherche biomédicale, Pipettage d'échantillons dans une boîte de Petri en laboratoire Banque D'Images

Analytical chemistry Photos Stock & Des Images
(4,650)Filtres rapides :
Analytical chemistry Photos Stock & Des Images

RFG3KPCF–Un échantillon contenant un eppendorf utilisé en chimie analytique et en attente d'extraction d'ADN dans un laboratoire d'essai

RFRJPPWM–Scientist examining flacon contenant l'échantillon utilisé en recherche biomédicale, de l'ADN, la biotechnologie, la chimie analytique, la recherche pharmaceutique

RF2FHN375–Équipement de titrage pour chimie analytique. Verrerie de laboratoire dans un laboratoire scientifique

RFRYY1F0–Le mélange et la préparation scientifique une solution chimique dans un tube à essai au cours d'une expérience dans le laboratoire.

RF2HKDFJJ–Banderole avec chimiste contenant un erlenmeyer ou un flacon conique en verre pour titration avec des liquides brillants avec espace de copie.Laboratoire de chimie analytique moderne

RF2YMYFDE–Instrumentation analytique avancée dans un laboratoire équipé de systèmes HPLC et de spectrométrie de masse

RF3C80X25–Les flacons de réactif avec bouchons rouges verts bleus sont posés sur une paillasse blanche dans le laboratoire, à côté de la verrerie

RF2RNRX7T–Spectrophotomètre : en chimie analytique et en science des matériaux, les spectrophotomètres analysent l'absorption ou la transmission de la lumière par une substance. TH

RF3AMK2CW–Le test Griess est un test chimique analytique qui détecte la présence d'ions nitrite en solution

RM2WC7KAK–TURIN, ITALIE - CIRCA JANVIER 2023 : Université de Turin, Faculté de chimie analytique signe

RFDGH236–La chimie analytique - de l'échantillon à la pipette dans tube à essai pour analyse en laboratoire

RF2M1HXRN–3D image de la formule squelettique vert de Pinacryptol - structure chimique moléculaire du colorant d'azine isolé sur fond blanc

RF2P92G45–TURIN, ITALIE - VERS JANVIER 2023: Université de Turin, Faculté de chimie analytique signe

RFDGH228–La chimie analytique - de l'échantillon à la pipette dans tube à essai pour analyse en laboratoire

RF2FHN526–Équipement de titrage pour chimie analytique. Verrerie de laboratoire dans un laboratoire scientifique

RF3CANJPY–Spécialiste du pipetage en blouse de laboratoire transférant le liquide sur paillasse de laboratoire avec micropipette et flacons

RFRYY1F1–Le mélange et la préparation scientifique une solution chimique dans un tube à essai au cours d'une expérience dans le laboratoire.

RF2HK7RBE–Banderole avec chimiste contenant un erlenmeyer ou un flacon conique en verre pour titration avec des liquides brillants avec espace de copie.Laboratoire de chimie analytique moderne

RF2YMYF8Y–Réactifs chimiques organisés et conteneurs sur étagères de laboratoire, fond de laboratoire de biochimie

RF2WG5P3C–une jeune femme dans un laboratoire de chimie analytique tient un support avec des tubes à essai dans les mains

RF3AMK2BP–Le test Griess est un test chimique analytique qui détecte la présence d'ions nitrite en solution

RF2K9754J–3D image de formule squelettique de permanganate de potassium - structure chimique moléculaire du composé inorganique isolé sur fond blanc

RMKKRH9G–La cartouche Gorskii 21026u est une cartouche d'extraction en phase solide (SPE) utilisée en chimie analytique pour la préparation d'échantillons. Il contient un poids de lit de 350 mg et un volume de 3 mL, adapté à diverses applications nécessitant des techniques de SPE.

RFDGH20Y–La chimie analytique - de l'échantillon à la pipette dans tube à essai pour analyse en laboratoire

RF2FHMYRD–Creusets en platine utilisés pour la préparation d'échantillons dans un laboratoire de chimie analytique. Équipement de laboratoire en métal brillant

RF3D0E8N2–Avec microscope noir debout sur paillasse avec flacons, tubes et doodles de formule, espace de copie

RF2HKJ1K8–Bannière avec flacons HPLC dans l'échantillonneur automatique.Laboratoire de chimie analytique moderne.

RF2YMYF8X–Réactifs chimiques organisés et conteneurs sur étagères de laboratoire, fond de laboratoire de biochimie

RF2K2WRP8–Chercheur avec tubes à essai chimiques de laboratoire en verre avec liquide pour le concept de recherche analytique, médicale, pharmaceutique et scientifique.

RMFY22JP–Chimiste analytique féminine, les cheveux gris, 50-55 ans, remplissage d'un mélange de produits chimiques de l'eau et le ferrocyanure de potassium dans un verre

RF3AMK2BK–Le test Griess est un test chimique analytique qui détecte la présence d'ions nitrite en solution

RF2AAWW78–Close-up d'échantillons de verser dans des flacons pour contrôles analytiques au laboratoire

RF2M21HM5–3D image de la formule squelettique de l'acide phtalique - structure chimique moléculaire de l'acide benzènedioïque isolé sur fond blanc

RMKT0E9H–Le spectrophotomètre Beckman Model DU, présenté dans le manuel de 1954, était un outil important dans la recherche scientifique, permettant une mesure précise de l'absorption de la lumière sur différentes longueurs d'onde. Il a joué un rôle important dans l'avancement de la chimie analytique et des études de laboratoire au milieu du XXe siècle.

RF2BD575J–Scientifique avec revêtement de laboratoire remplissant un tube de test sur l'équilibre analytique avec des produits chimiques dans le laboratoire

RFG3KPCG–Un échantillon contenant un eppendorf utilisé en chimie analytique et en attente d'extraction d'ADN dans un laboratoire d'essai

RF2FHMYA7–Creusets en platine utilisés pour la préparation d'échantillons dans un laboratoire de chimie analytique. Équipement de laboratoire en métal brillant

RF3C17WR1–Techniciens de laboratoire en blouse inspectant des échantillons au microscope et pipettant des liquides bleus et oranges en laboratoire

RF2J5Y610–Le scientifique place les microtubes à centrifuger dans la centrifugeuse pour la séparation de phase. Analyse métabolomique et lipidomique dans le laboratoire de chimie analytique.

RF2YMYFCN–Réactifs chimiques organisés et conteneurs sur étagères de laboratoire, fond de laboratoire de biochimie

RF2K2WR69–Chercheur avec tubes à essai chimiques de laboratoire en verre avec liquide pour le concept de recherche analytique, médicale, pharmaceutique et scientifique.

RF2FWH6PP–Différentes solutions colorées dans un flacon conique dans un laboratoire de chimie avec un arrière-plan flou de la chimie organique expérimentez la photographie pour une utilisation en arrière-plan

RF3AMK2C2–Le test Griess est un test chimique analytique qui détecte la présence d'ions nitrite en solution

RF2AAWPKR–Échantillons étant versé depuis dans des flacons pipette pour contrôles analytiques au laboratoire

RF2M1MCDB–3D image de la formule squelettique Safranin - structure chimique moléculaire de la coloration biologique isolée sur fond blanc

RFG3KPCE–Un échantillon contenant un eppendorf utilisé en chimie analytique et en attente d'extraction d'ADN dans un laboratoire d'essai

RFD9NX7N–Vue générale d'un laboratoire de chimie avec une table de travail et tableau noir avec des formules sur-le sur l'arrière-plan

RF2FHN1N9–Creusets en platine utilisés pour la préparation d'échantillons dans un laboratoire de chimie analytique. Équipement de laboratoire en métal brillant

RF3AY03Y1–Le scientifique utilise la pipette sur la flamme du brûleur Bunsen dans le laboratoire de chimie de conception plate, thème de la technologie

RF2J5NM86–Le scientifique place les microtubes à centrifuger dans la centrifugeuse pour la séparation de phase. Analyse métabolomique et lipidomique dans le laboratoire de chimie analytique.

RF2K2WR6A–Chercheur avec tubes à essai chimiques de laboratoire en verre avec liquide pour le concept de recherche analytique, médicale, pharmaceutique et scientifique.

RF2FWH6PJ–Différentes solutions colorées dans un flacon conique sur un banc dans un laboratoire de chimie avec un arrière-plan flou de photographie d'expérience de chimie organique pour backgroun

RF3A51HA4–Scientifique professionnel dans un laboratoire de science médico-légale effectuant des tests d'échantillons de sérum. Un cliché recadré met en évidence le matériel de laboratoire et le travail analytique dans une enquête criminelle ou dans un contexte biotechnologique. Idéal pour la science, la recherche et les thèmes de flux de travail de laboratoire.

RF2AAWFCG–Close-up d'échantillons est versé à partir de pipetter en flacons pour contrôles analytiques au laboratoire

RF2M1MCCN–3D image de la formule squelettique de la phénosafranine - structure chimique moléculaire du pinasafrole fluorochrome isolé sur fond blanc

RF2RD2512–test de flamme. la procédure de chimie analytique a utilisé la couleur de la flamme pour identifier les éléments chimiques ou les ions métalliques. spectre d'émission de flamme. scientifique

RFDGH20E–La chimie analytique - de l'échantillon à la pipette dans tube à essai pour analyse en laboratoire

RFD9NX68–Macro d'une élève dans un laboratoire de chimie faisant des expériences sur les plantes et insectes